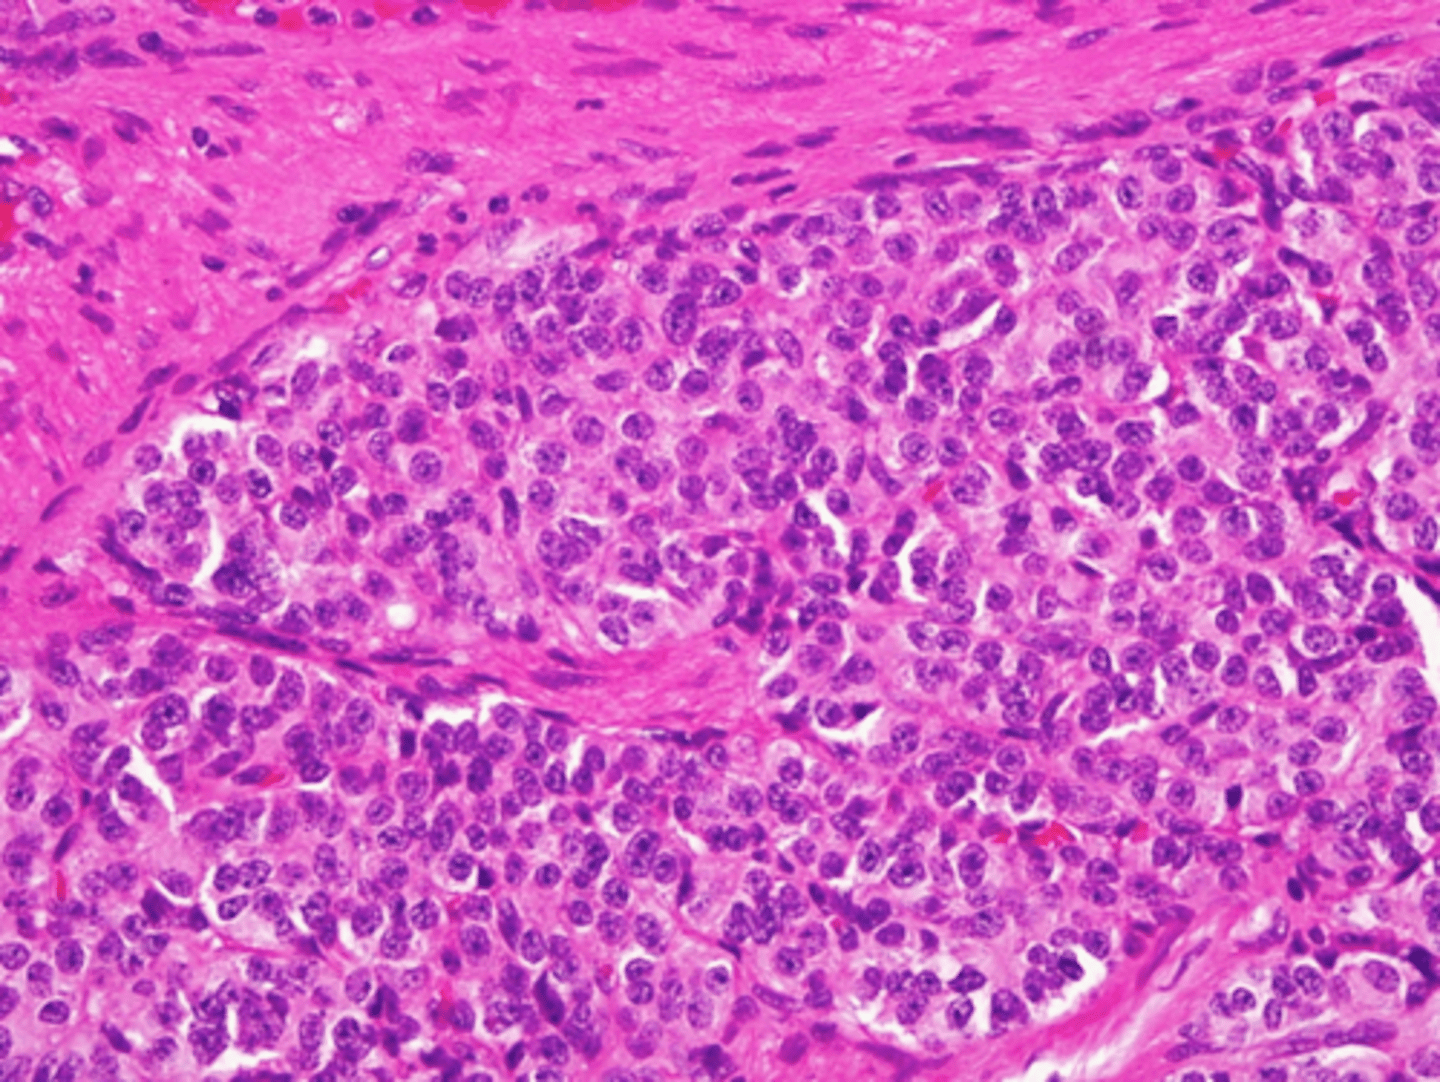
knowt flashcard image

1/46
Looks like no tags are added yet.
Name | Mastery | Learn | Test | Matching | Spaced | Call with Kai |
|---|
No analytics yet
Send a link to your students to track their progress
Tracheoesophageal atresia

Pulmonary infarct

Emphysema

pleural bleb

Bullae

Bronchiectasis

bronchiectasis

cystic fibrosis

Bronchopneumonia

Lobar pneumonia

Tuberculosis

aspergilloma

Hamartoma

bronchopneumonia

lobar pneumonia

Tuberculosis

hamartoma

cystic fibrosis

Small cell carcinoma

Small cell carcinoma

Small cell carcinoma

hamartoma

adenocarcinoma in situ

adenocarcinoma

adenocarcinoma

adenocarcinoma

SCC

SCC

Carcinoid

Mesothelioma

SCC

Mesothelioma

Mesothelioma

Mesothelioma

Mesothelioma

Carcinoid

Carcinoid
SCC

SCC

Adenocarcinoma

adenocarcinoma in situ

Small cell carcinoma

Hamartoma

Aspergilloma

Tuberculosis

Tuberculosis

Sarcoidosis
